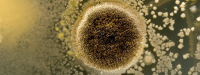
Schimmeleiwit goed voor het hart

trefwoord
| Verschenen in | ||
|---|---|---|

|
Paleovoeding geassocieerd met minder sterfte | nieuwsbrief nr. 537 |

|
Glykemische index in mega-studies | nieuwsbrief nr. 525 |

|
Microplastics in atherosclerotische plaques | nieuwsbrief nr. 520 |

|
Ultra-bewerkt en ultra-gevaarlijk? | nieuwsbrief nr. 518 |

|
Eieren: voedzaam, veilig en duurzaam | nieuwsbrief nr. 499 |
|
Mycoproteïne verlaagt cardiovasculaire ziektemarkers | nieuwsbrief nr. 496 |

|
Vitamine K tegen vasculaire calcificatie | nieuwsbrief nr. 498 |

|
Meer stappen, minder kans op overlijden | nieuwsbrief nr. 493 |

|
Diagnostiek rondom hart- en vaatziekten in de complementaire praktijk | Voedingsgeneeskundejg. 24nr. 5 |

|
B-vitaminen verlagen sterftekans door calciumantagonisten | nieuwsbrief nr. 478 |
Paginering
- Vorige pagina
- Pagina 2
- Volgende pagina